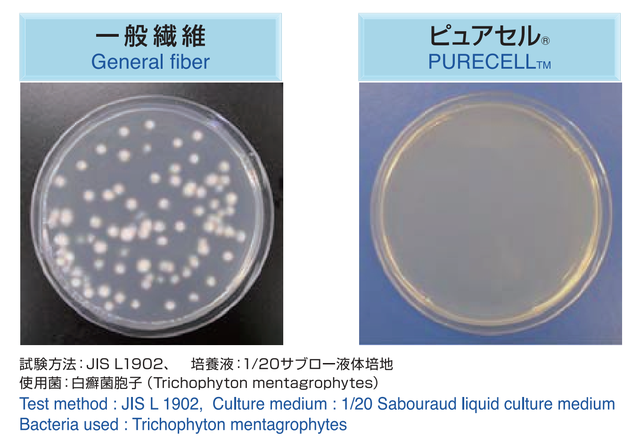

プロジェクト実行者
ストーリー
- こだわりの日本品質:高吸水性素材と防水素材を採用し、吸水速乾性も◎
- 手洗いできてサステナブル:繰り返しの使用が可能、地球のことを考えた選択を
- 40代女性が作る「履き心地」「ちょい漏れ吸収」にこだわった渾身のショーツ

お客様のご要望にお応えし、今回は吸水型ショーツのプロフェッショナル技術を持つ工場とともに日本の繊維技術を惜しみなく使った吸収型ショーツを開発しました。



「ランシール®」「AQUA®」「ピュアセル®」を不織布で複合した素材を
吸水布として使用しています。
日本の繊維技術の吸水・速乾・抗菌防臭を兼ね備えた繊維です。
「ランシール®」「AQUA®」「ピュアセル®」は東洋紡株式会社の登録商標です。


「ランシール®」はアクリル繊維の表面を吸水ポリマーで覆ったユニークな繊維です。(映像は実速度です)

今回の製品はこのランシール®を使用して、より吸水性を追い求めました。

さらに、「AQUA®」という吸水拡散性に優れた繊維を混用することで、吸水効果を高めることに成功しました。


*今回は「AQUA®」単体での使用ではありません。他素材との混紡になります。

「ピュアセル®」は、銀イオンをアクリル繊維に保持させた、除菌力に優れた除菌繊維です。銀イオンの効果で、キレイを保ちます。

多い日用と同じ長さの吸収布、ウエストまでの防水布で漏れをストップします。

「プロのこだわり仕様」
今までの吸収型ショーツは 布の中心ではなく、縫い目から漏れるのが問題でした。 また「縫い目がない接着型は接着面が硬くお肌に合わない」というお声も。そこで 直接接着面が肌にあたらず、針穴からの漏れも防ぐ特殊な仕様を考えました。
▼縫い目から漏れることを避けるため、吸水布と防水布を接着し、吸水布には針孔がない仕様に仕上げました。



▲カラーはブラックのみになります









※Girls Leapはジュニアサイズをご用意しております
ジュニア:ヒップ82~90
https://www.makuake.com/project/girlsleap


1974年生まれ、大阪府出身。中学生の娘を持つママです。
大学卒業後、11年間の会社勤めを経て、現在レディスアパレルの企画・生産会社を営んでいます。
前回のmakuakeでご支援いただいたGirls Leapでの経験を活かし、
ママたちにもお使いいただける「吸水型ショーツ」をお届けします。
是非、多くの方のお手にとっていただけると幸いです。

ーーーーーーーーーー
Q:お手入れの方法は?
A:着用後 すぐに30分以上水につけてください。
(気になる方は重曹と一緒につけ置きしてください)
その後洗濯機で洗えます。
乾燥機・柔軟剤はご使用いただけません。
ーーーーーーーーーー
Q:返品・交換は可能ですか?
A:本製品は直接肌に着ける衛生商品の為、返品・交換は対応いたしかねます。
初期不良の場合は 商品到着後1週間以内にご連絡をお願いします。
ーーーーーーーーーー
Q:日本国外への発送は可能ですか?
A:4枚セットは海外発送いたします。ご支援いただいたのち発送について
ご連絡いたします。
ーーーーーーーーーー
リスク&チャレンジ
本プロジェクトの商品は、5月末までに配送を完了する予定です。 プロジェクト終了後には迅速に配送手配を開始致します。 ※ご注文状況、使用部材の供給状況、製造工程上の都合等により出荷時期が遅れる場合があります。 その際、活動レポートにてご報告させていただだきます。 ※開発中の製品につきましては、デザイン・仕様が一部変更になる可能性もございます。 ※本プロジェクトを通して想定を上回る皆様からご支援を頂き、現在進めている環境から量産体制を更に整えることができた場合、正規販売価格が販売予定価格より下がる可能性もございます。 クラウドファンディングの性質上、以上の注意点につきましてあらかじめご理解とご了承いただいた上でご支援くださいますよう、よろしくお願い申し上げます。
サポーターからの応援コメント
文章のトップに戻る
応援購入する
このプロジェクトはAll in型です。目標金額の達成に関わらず、プロジェクト終了日の2021年04月09日までに支払いを完了した時点で購入が成立します。
【早割】Mam Leap×1枚

2,970円(税込)
・Mam Leap×1枚
[一般販売予定価格 3,300円の10%OFF]
※皆様の応援購入により量産効率が向上した場合、正規販売価格が販売予定価格より下がる可能性もございます。
※デザイン・仕様は変更になる可能性もございます。ご了承ください。
※ご注文状況、使用部材の供給状況、製造工程上の都合等により出荷時期が遅れる場合があります。
【早割】Mam Leap×2枚

5,610円(税込)
・Mam Leap×2枚
[一般販売予定価格 6,600円の15%OFF]
※皆様の応援購入により量産効率が向上した場合、正規販売価格が販売予定価格より下がる可能性もございます。
※デザイン・仕様は変更になる可能性もございます。ご了承ください。
※ご注文状況、使用部材の供給状況、製造工程上の都合等により出荷時期が遅れる場合があります。
【早割】Mam Leap×3枚

7,920円(税込)
・Mam Leap×3枚
[一般販売予定価格 9,900円の20%OFF]
※皆様の応援購入により量産効率が向上した場合、正規販売価格が販売予定価格より下がる可能性もございます。
※デザイン・仕様は変更になる可能性もございます。ご了承ください。
※ご注文状況、使用部材の供給状況、製造工程上の都合等により出荷時期が遅れる場合があります。
【Makuake割】Mam Leap×3枚

8,415円(税込)
・Mam Leap×3枚
[一般販売予定価格 9,900円の15%OFF]
※皆様の応援購入により量産効率が向上した場合、正規販売価格が販売予定価格より下がる可能性もございます。
※デザイン・仕様は変更になる可能性もございます。ご了承ください。
※ご注文状況、使用部材の供給状況、製造工程上の都合等により出荷時期が遅れる場合があります。
【早割】Mam Leap×4枚

9,900円(税込)
・Mam Leap×4枚
[一般販売予定価格 13,200円の25%OFF]
※皆様の応援購入により量産効率が向上した場合、正規販売価格が販売予定価格より下がる可能性もございます。
※デザイン・仕様は変更になる可能性もございます。ご了承ください。
※ご注文状況、使用部材の供給状況、製造工程上の都合等により出荷時期が遅れる場合があります。
【Makuake割】Mam Leap×4枚

10,560円(税込)
・Mam Leap×4枚
[一般販売予定価格 13,200円の20%OFF]
※皆様の応援購入により量産効率が向上した場合、正規販売価格が販売予定価格より下がる可能性もございます。
※デザイン・仕様は変更になる可能性もございます。ご了承ください。
※ご注文状況、使用部材の供給状況、製造工程上の都合等により出荷時期が遅れる場合があります。
【Makuake割】Mam Leap×2枚+Girls Leap×2枚

10,800円(税込)
・Mam Leap×2枚+Girls Leap×2枚
[一般販売予定価格 14,400円の25%OFF]
※Girls Leap×2枚はジュニアサイズになります
(ジュニア:ヒップ82~90)
※皆様の応援購入により量産効率が向上した場合、正規販売価格が販売予定価格より下がる可能性もございます。
※デザイン・仕様は変更になる可能性もございます。ご了承ください。
※ご注文状況、使用部材の供給状況、製造工程上の都合等により出荷時期が遅れる場合があります。
「Makuake(マクアケ)」は、実行者の想いを応援購入によって実現するアタラシイものやサービスのプラットフォームです。このページは、 ファッションカテゴリの 「吸水型生産のプロが日本の繊維技術を惜しみなく使った渾身のショーツ」プロジェクト詳細ページです。






